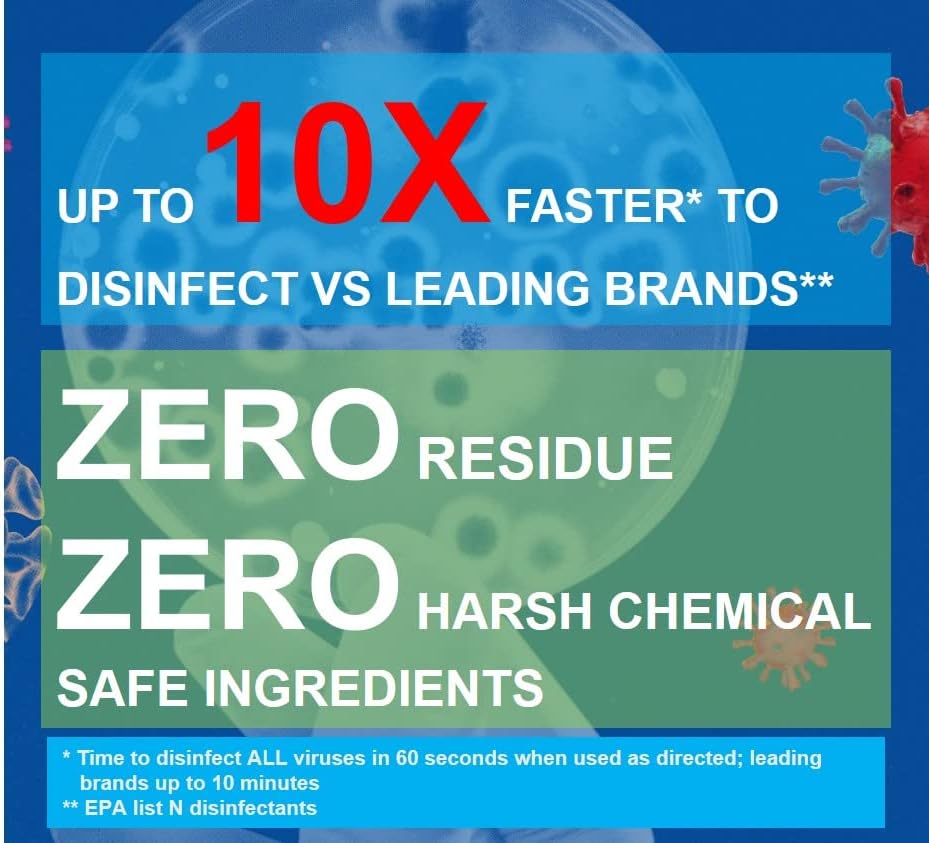
Purefypro Disinfectant Spray (4oz) - Kills 99.9999% Viruses HIV, Monkeypox, Hepatitis, Norovirus, VRE, MRSA, No Rinse, No Residue. Suitable for All Surfaces

PUREFYLIFE
Purefypro Disinfectant Spray (4oz) - Kills 99.9999% Viruses HIV, Monkeypox, Hepatitis, Norovirus, VRE, MRSA, No Rinse, No Residue. Suitable for All Surfaces
Purefypro Disinfectant Spray (4oz) - Kills 99.9999% Viruses HIV, Monkeypox, Hepatitis, Norovirus, VRE, MRSA, No Rinse, No Residue. Suitable for All Surfaces
Couldn't load pickup availability
Overview
- Brand : PUREFY
- Item Form : Spray
- Item Volume : 4 Fluid Ounces
- Unit Count : 4 Fluid Ounces
- Surface Recommendation : Fabric
Share






Cleaning Supplies
-
SC Johnson Professional Fantastik No Rinse Disinfectant & Food Surface Sanitizer 32oz
Regular price $17.45 USDRegular priceUnit price / per -
Nu-Foam Sanitizing Tablets for Bar Glassware – Superior Rinse Aid - Hand Washing Bar, Tavern, Brewery Supplies - Spotless Serving Glasses -2 Pack 200 Tablets - Makes 1,200 Quarts Sanitizing Solution
Regular price $65.80 USDRegular priceUnit price / per -
DilaBee Plastic Spray Bottle (2 Pack) - 16oz Empty Spray Bottles for Cleaning, Gardening & Grilling - Leakproof & Adjustable Nozzle Water Spray Bottle - Heavy Duty & BPA Free Plastic Spray Bottles
Regular price $16.49 USDRegular priceUnit price / per -
1 Bottle Steramine Sanitizer Tablets - Multi Purpose Steramine Sanitizing Tablets for Food Contact Surfaces in Kitchen, Diners, Hotels, Restaurants & Food Trucks by FryOilSaver Co. (150 Count)
Regular price $16.47 USDRegular priceUnit price / per
Cleaning Collection
-

Abrasive Brushes
Discover the perfect blend of durability and precision with CleanHub’s Abrasive Brushes,...
-

Air Fresheners
Elevate your driving experience with CleanHub’s premium air fresheners, designed to bring...
-

Cleaning & Maintenance
Keep your automotive and RV essentials in top condition with CleanHub’s Cleaning...
✨ Clean Living. Clean Spaces. CleanHub. ✨
Whether you’re maintaining your home, running a business, or stocking up on everyday essentials, CleanHub is here to keep your spaces spotless and stress-free.
Blog post
-

Spring Cleaning Anytime: A Simple Checklist Usi...
Who says spring cleaning has to wait until spring? With the right mindset — and the right products — you can refresh your home any time of year. Whether it’s...
Spring Cleaning Anytime: A Simple Checklist Usi...
Who says spring cleaning has to wait until spring? With the right mindset — and the right products — you can refresh your home any time of year. Whether it’s...
-

The Truth About Toxic Cleaners – And What to Us...
Keeping your home clean shouldn’t come at the expense of your health or the environment. But the truth is, many conventional cleaning products are filled with toxic chemicals that pollute...
The Truth About Toxic Cleaners – And What to Us...
Keeping your home clean shouldn’t come at the expense of your health or the environment. But the truth is, many conventional cleaning products are filled with toxic chemicals that pollute...
-

7 Eco-Friendly Cleaning Swaps That Make a Big D...
In a world where sustainability matters more than ever, even small changes in your daily routine can have a lasting impact. One of the easiest places to start? Your cleaning...
7 Eco-Friendly Cleaning Swaps That Make a Big D...
In a world where sustainability matters more than ever, even small changes in your daily routine can have a lasting impact. One of the easiest places to start? Your cleaning...
Frequently Asked Questions

How long does shipping take?
Shipping takes place within 3-5 business days. If there is a problem with the shipment of the product, we will notify you via the email address you entered when ordering.
Is free shipping available?
We do not currently offer free shipping. However, this may be added at some point. We apologize.
How can I get a tracking number for my order?
If your order has been shipped, we will add the tracking number to your order and notify you via the email address you entered when ordering.
How do I process a return or exchange?
For returns or exchanges, please contact us within 14 days of receiving the product, along with a receipt or screenshot of the purchase, and a photo of the product with the packaging or tag intact.